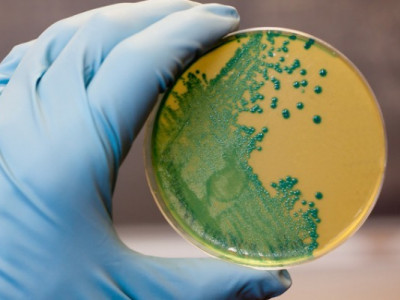

Нижчий розум: Як кишкові бактерії керують мозком
- Останні
- Популярні
- Вересень, 13
-
- Вересень, 12
-
- Вересень, 11
-
-
- Вересень, 10
-
-
-
-
-
-
-
-
- Вересень, 09
-
-
- Вересень, 08
-
-
-
-
-
Більше новин
Більше новин
Новини по днях
Сьогодні,
15 вересня 2025
15 вересня 2025
Новини на тему
Більше новин